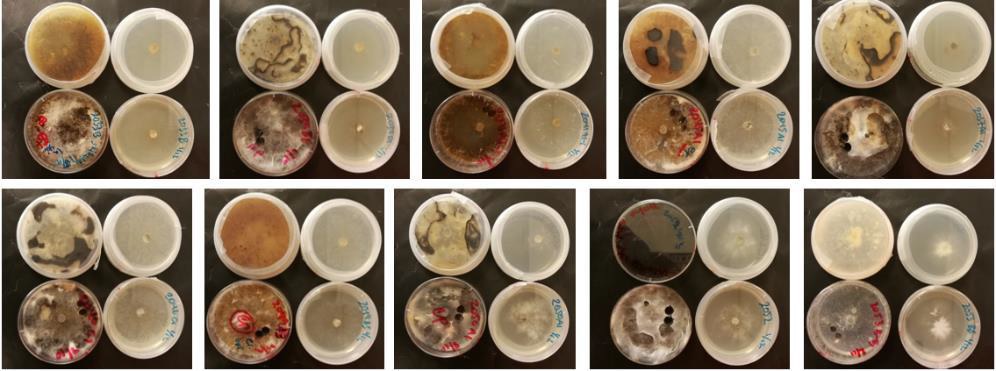

Le projet de recherche « IPM-Golf 2020-2023 » lancé en 2020 vise à investiguer les pratiques culturales, les produits alternatifs et les nouvelles technologies qui permettraient de contrôler la fusariose nivale et le dollar spot sans pesticides. Il s’intéresse aussi aux solutions contre les larves de hannetons et de tipules. Nous détaillons dans cet article les avancées du projet.

Fondée en 2006 par les fédérations de golf et les associations de greenkeepers nordiques, la Scandinavian Turfgrass and Environment Research Foundation (STERF) est une fondation indépendante qui soutient la Recherche & Développement menée autour de la gestion des gazons sur les golfs, et plus largement pour l’ensemble de la filière gazons sportifs professionnels. Depuis de nombreuses années, le STERF a fait de la lutte intégrée l’une de ses principales priorités de recherche.
Le projet « IPM-Golf 2020-2023 » en détail
Le projet « IPM-Golf 2020-2023 » est financé par le STERF et le R&A, mais aussi les fédérations de golf d'Allemagne et des Pays-Bas et l'Agence de protection environnementale danoise. Il implique des chercheurs et des greenkeepers scandinaves, allemands, anglais, portugais et russes, ainsi que les fournisseurs ICL, Syngenta, Suståne et Aqua Yield.
Lancé en 2020, il vise à identifier des méthodes de lutte contre les deux principales maladies des greens de golfs, à savoir la fusariose nivale et le dollar spot. La fusariose nivale (plus connue à l’étranger sous le terme « microdochium patch »), causée par le champignon Microdochium nivale, est la maladie la plus impactante d’un point de vue économique sur les gazons des pays nordiques. De son côté, le dollar spot est une maladie causée par quatre espèces de champignons du genre Clarireedia, que l’on trouve principalement sur les terrains de golf d’Amérique du Nord et d’Europe Centrale et du Sud. Mais des recherches ont récemment confirmées que le dollar spot est aussi présent en Scandinavie.
Le projet inclut également un volet sur les larves des hannetons et de tipules, deux insectes nuisibles qui peuvent causer beaucoup de dégâts sur les parcours de golfs. Avec l’interdiction en Europe de la plupart des insecticides permettant de lutter contre ces ravageurs, la recherche d’alternatives est une nécessité.
Les objectifs détaillés du projet sont les suivants :
- Étudier l'effet des approches culturales telles que le roulage sur le microdochium patch, le rayonnement UV-C et les produits alternatifs contre le microdochium patch et le dollar spot.
- Identifier les espèces fongiques responsables du dollar spot en Europe Centrale et du Nord et mettre au point des méthodes d’identification rapide des espèces de Clarireedia spp. et Microdochium nivale dans les tissus végétaux mais aussi dans les semences commerciales, afin de déterminer si elles peuvent constituer une source potentielle de propagation du dollar spot en Europe.
- Effectuer une revue de la littérature sur les méthodes de lutte existantes et les innovations potentiellement intéressantes pour améliorer la surveillance, l'alerte et le contrôle des larves de hanneton et de tipule.
En mai-juin 2020, des essais sur le terrain ont ainsi été lancés autour de ces différents thèmes au Danemark (1), en Norvège (2), au Royaume-Uni (2) et en Allemagne (2).
Effet du roulage sur la fusariose nivale
Une expérimentation a été menée en 2020 et 2021 sur un green du Copenhagen Golf Course (Danemark) pour examiner les effets d'un roulage léger sur le développement du microdochium patch (MP). Le green était constitué d’un mélange de fétuques rouges et d’agrostide stolonifère, avec une part importante de fétuques. Ils ont testé l’effet de la fréquence de roulage (0, deux fois par semaine, 4 fois par semaine) et de sa durée (de juin à novembre et d’août à novembre).
Les résultats de 2020 ont montré que le roulage a réduit de manière significative le MP, avec des tâches sur 5 % de la surface des parcelles non roulées contre seulement 2,0 % et 2,3 % de la surface sur les parcelles roulées deux ou quatre fois par semaine. Le roulage a aussi amélioré l’aspect visuel du gazon à partir d’août. En revanche, aucune différence significative n’a été constaté pour l’attaque de MP et l’aspect visuel entre les différentes modalités de roulage.
En 2021, il n’y a malheureusement pas eu d’attaque de fusariose sur le green expérimental pour confirmer ces premiers résultats.
L'expérience semble donc indiquer qu'un roulage léger deux fois par semaine d'août à novembre peut réduire l'attaque de la fusariose nivale sur les greens de golfs scandinaves à forte dominance de fétuques rouges.
Effet des UV-C sur la fusariose nivale et le dollar spot
Cet essai, lancé en 2020 au Osnabrück Golf Club (Allemagne) sur un green composé d’agrostide stolonifère et de pâturin annuel, vise à tester l'efficacité du rayonnement UV-C pour contrôler la fusariose nivale et le dollar spot. Le rayonnement a été appliqué avec un matériel SGL UVC 180, à 3 doses (7-8 mJ/cm², 35-40 mJ/cm² et 70-80 mJ/cm²). Ce traitement est appliqué 3 fois par semaine, de mai 2020 à mai 2022 (avec un ajustement de novembre à avril en fonction des conditions climatiques et de l’apparition de la fusariose).
Les résultats de la saison 2020 ne montrent pas de différence significative entre les différentes modalités. Il semblerait juste que les dosages les plus forts (40 et 80 mJ/cm²) ont « tendance » à réduire le développement du dollar spot sur les greens. Les résultats préliminaires de 2021 semblent confirmer cette tendance.
Essais de produits alternatifs contre la fusariose
Des essais terrains ont été menés au centre de recherche du NIBIO à Landvik (Norvège) et sur celui du STRI à Bingley (UK) pour évaluer les effets de produits alternatifs sur la prévention et le contrôle de la fusariose sur greens de golf. Les résultats présentés sont ceux de la saison 2020-2021.
NIBIO
A Landvik, quatorze traitements ont été appliqués sur des greens « USGA » en pâturin annuel. Ont ainsi été testées des doses réduites de fongicides, de l’acide citrique appliqué sur des durées variables, du sulfate de fer à deux doses, des modulations au niveau de la fertilisation azotée, un engrais organique à libération lente (Sustane) et du roulage à deux doses d’azote. La fusariose est apparue en octobre 2020, avec un développement important jusqu’en mars 2021.
Le roulage en octobre (trt. 15 « Rolling, low N ») et l’application d’acide citrique d’août à octobre (trt.7 « Citric acid, août-oct. ») semblent être les produits alternatifs les plus efficaces pour réduire sur le long terme l’attaque de fusariose. Une réduction de l’apport d’azote de 250 kg/ha/an en standard à 180 kg/ha/an (trt. 11 Low maintenance) a réduit de moitié l’attaque de fusariose, mais a aussi augmenté l’attaque d’anthracnose.
A noter que l’application du fongicide à 60 % de la dose recommandée se montre presque aussi efficace que la dose standard.
STRI
Les essais du STRI se sont fait sur un green avec un sol naturel sableux, dont le gazon était constitué de 60 % d’agrostide capillaire et de 40 % de pâturin annuel. Il est particulièrement sensible à la fusariose, qui se développe principalement en automne et hiver. Les traitements testés sont similaires à ceux de Landvik, avec une dose standard d’azote inférieure (122 kg/ha/an).
Les résultats montrent que les fongicides ont été efficaces pour contrôle la fusariose, même sur le pic tardif de décembre. Le traitement à base de sulfate de fer concentré (trt.9) s’est montré particulièrement efficace contre la fusariose. Mais les auteurs précisent que son effet n’a pas duré sur l’hiver suivant. L’application de l’engrais organique à libération lente (trt. 12) n’a été d’aucune efficacité contre l’infection initiale de septembre 2020 mais a aidé le gazon à contenir la maladie durant le second pic de décembre.
Identification des espèces de DS et MP
En 2020, le NIBIO a reçu 45 échantillons de gazon présentant des symptômes de dollar spot venant du Danemark, de Suède, Norvège, Royaume-Uni, Portugal, Espagne et Allemagne. Les champignons ont été récupérés à partir de 16 échantillons, mis en culture et envoyés pour analyse moléculaire.
Pour l’heure, la présence de Clarireedia spp. dans les 16 échantillons a été confirmée en se basant sur leurs ITS (région de l’ARNr servant de code-barres pour les champignons). D’autres champignons pathogènes ont été identifiés : Fusarium spp., Rhyzoctonia spp., Limonomyces roseipellis et Waitea circinate. Les données seront analysées de manière plus approfondies cet hiver.
Culture pure des Clarireedia spp. collectées et isolées à partir des échantillons reçus des différents pays européens.
Pour le dosage immunologique et l'identification de Microdochium nivale dans les tissus végétaux, les immunisations d’animaux par des extraits fongiques ont été achevés et la validation préliminaire du prototype ELISA pour Microdochium nivale est en cours en Finlande et en Russie.
Etude sur les larves de hannetons et les tipules
Un sondage réalisé en 2020 sur la période 2018-2020 montre que les problèmes de hannetons et de tipules sont plus marqués au Danemark qu’en Suède :
Au Danemark, il est légal d'utiliser l'insecticide Avaunt (indoxacarbe), qui bénéficie d’une homologation pour les usages mineurs contre les tipules du 15 septembre au 1er décembre. Le Gnatrol SC, à base de Bacillus thuringiensis, est aussi approuvé pour un usage mineur avec 1 à 3 traitements à l’automne contre les larves de petits insectes. Dans le printemps, il peut également être utilisé si le traitement à l'automne n'a pas été suffisant.
En 2020, aucun pesticide n'est autorisé contre les larves du hanneton (le Merit turf, à base d’imidaclopride, a été banni en 2019).
Différentes pratiques culturales comme l'utilisation d'engrais organiques, de ray-grass avec endophytes ou l'irrigation ont montré un certain contrôle des ravageurs. Des expériences de 2003 avec des nématodes et des champignons entomopathogènes ont montré un contrôle limité des ravageurs (Larsen & Ravn, 2003). La pulvérisation de ces solutions est indispensable pour avoir de bons résultats. L'efficacité des nématodes entomopathogènes (EPN) dans la lutte contre les insectes ravageurs en extérieur peut être améliorée grandement en jouant sur la formulation, la technique d’application et les espèces d’EPN utilisées. L'élevage d’espèces adaptées au climat nordique est l’un des défis. Les performances des solutions EPN disponibles n’ont pas encore été testées en conditions réelles sur les hannetons et les tipules. Ces travaux devraient être menés au cours des prochaines années.
Pour aller plus loin :
- Consulter l’intégralité des résultats présentés dans cet article : Rapport annuel du NIBIO 2022
- Consulter l’ensemble des projets de recherche, passés et en cours, soutenus par le STERF : http://www.sterf.org/sv/projects/project-list?pid=13